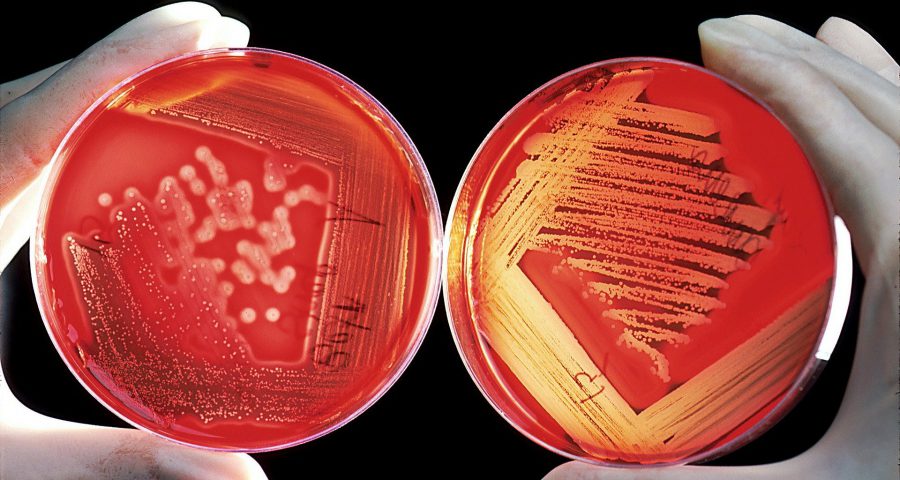

Egal ob bei der Routineuntersuchung oder der Untersuchung auf eine bestimmte Krankheit: Hin und wieder kommt es vor, dass beim Tierarzt ein Blutbild, eine klinisch-chemische Untersuchung des Urins oder die genaue Untersuchung von Kot oder Abstrichen angefertigt werden muss, um bestimmte Werte zu erhalten, damit der/die Tierärzt*in eine Aussage darüber treffen kann, ob das Kaninchen eine bestimmte Krankheit hat oder nicht. Neben der Sicherung einer Diagnose hilft eine Laboruntersuchung u. U. auch bei der Aussage darüber, wie weit die Erkrankung bereits fortgeschritten ist.
Bekommt man als Kaninchenhalter*in jedoch bestimmte Laborwerte vorgelegt, so kann man mit all den Fachbegriffen oft wenig anfangen und auch der Zusammenhang, warum bestimmte Werte für eine Krankheit sprechen o.Ä., bleibt für die Besitzer des Kaninchens oft unklar.
Daher beschäftigen sich die folgenden Infotexte damit, was bei laborchemischen Untersuchungen eigentlich genau passiert. Dabei soll nacheinander zunächst auf die Blutuntersuchung, dann auf die Harnanalyse und schließlich auf die Kotuntersuchung und gesonderte mikrobiologische Untersuchungen eingegangen werden.